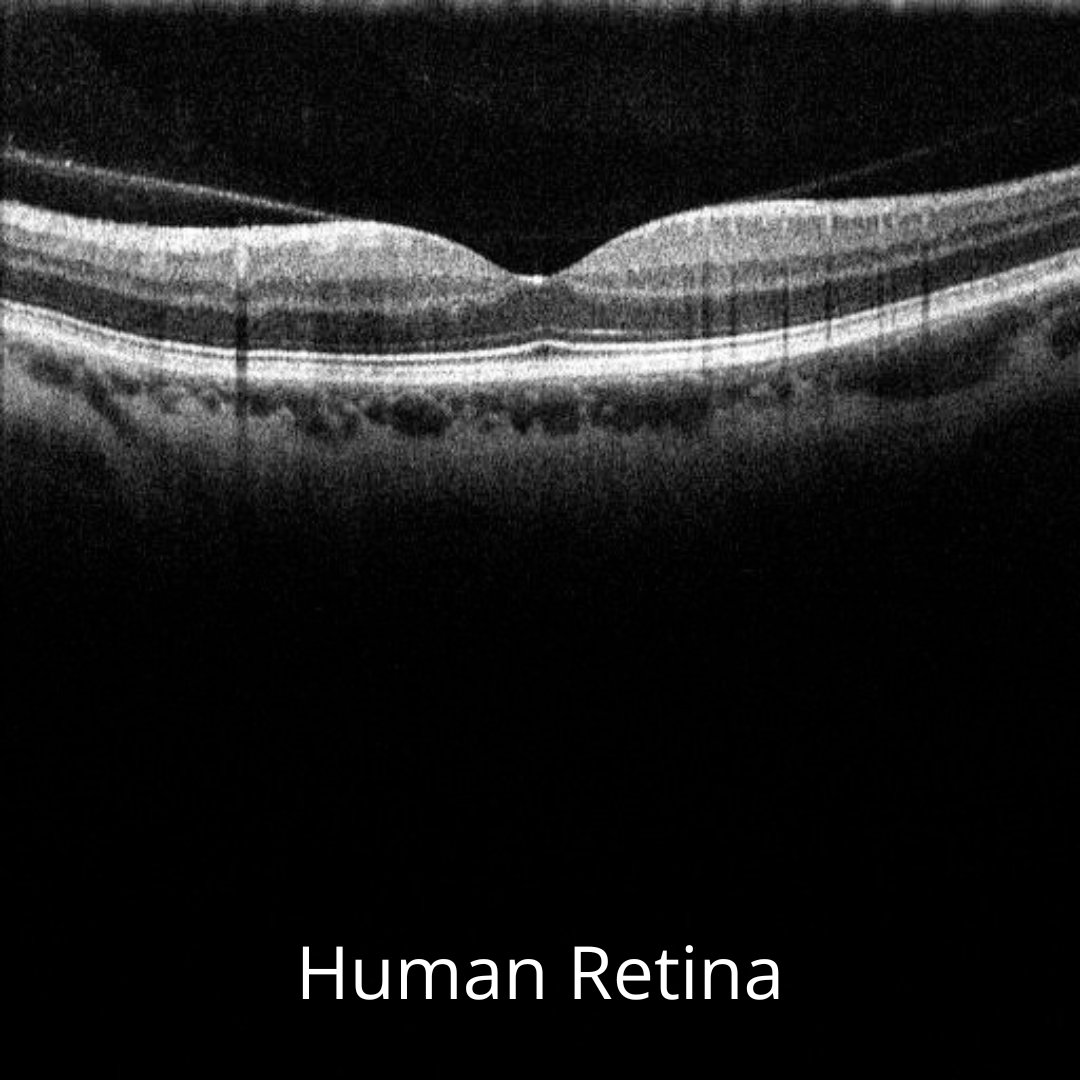
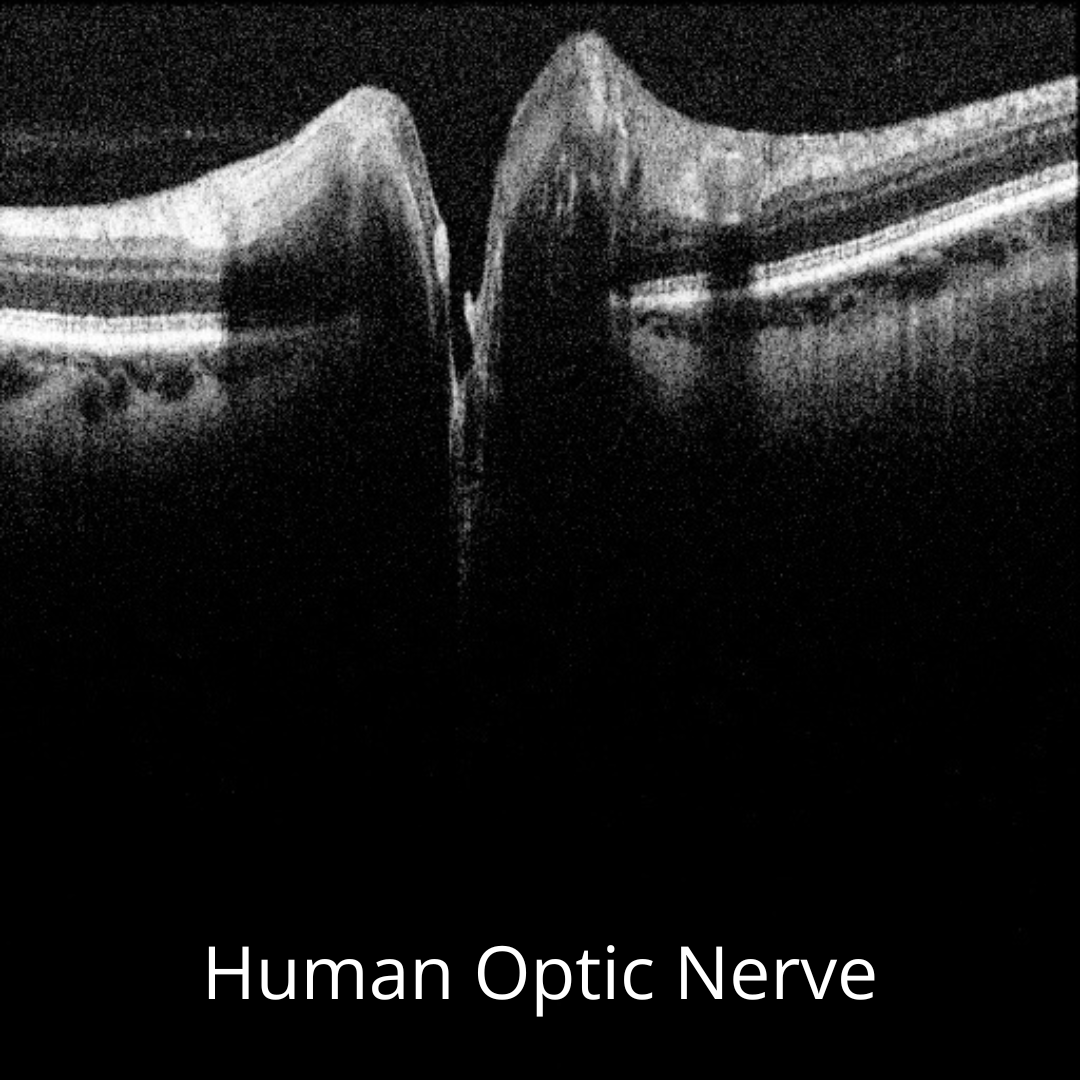

OQ ViewScope
Re-imagining retinal optical coherence tomography.
(For research use only)
Starting at $15,995
Performance
A patent-pending, low-cost, light-weight system has been devised that will revolutionize eye disease detection
OCT Scans with the OQ ViewScope